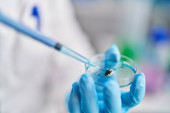

Młody Afroamerykanin w mundurze naukowca używający pipety w laboratorium

Informacje o pliku:
| Numer pliku: | 0101619085520 |
| Typ pliku/format: | Zdjęcia ( JPG ) |
| Rozdzielczość: | 9504x6336 (80,47x53,64 cm 300 dpi) |
| Kategorie: | |
| Autor: | Krakenimages.com |